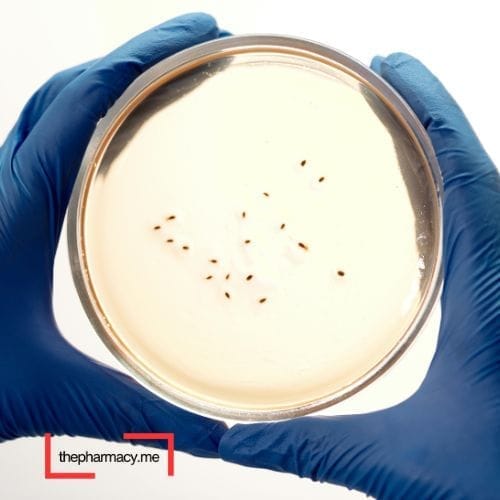

جرثومة المعدة (Helicobacter pylori) هي نوع من البكتيريا تُصيب بطانة المعدة، وتُعد من أكثر الأسباب شيوعًا لقرحة المعدة والالتهاب المزمن.
في هذا المقال، سنوضح كل ما تحتاج معرفته: كيف تنتقل؟ ما أعراضها؟ كيف يتم التشخيص؟ وما هو أفضل علاج فعّال لها حسب أحدث التوصيات.
ما هي جرثومة المعدة؟
هي بكتيريا حلزونية الشكل، قادرة على العيش في بيئة المعدة الحامضية، حيث تفرز إنزيمات تقلل الحموضة لحماية نفسها. تسبب التهابات في جدار المعدة، وقد تتطور إلى تقرحات أو حتى أورام في بعض الحالات المزمنة.
كيف تنتقل جرثومة المعدة؟
ملامسة لعاب أو قيء شخص مصاب
الطعام أو الماء الملوث
استخدام أدوات طعام غير نظيفة
سوء النظافة الشخصية أو الصحية
أبرز أعراض جرثومة المعدة
ليست كل الحالات تظهر عليها أعراض، لكن عند ظهورها تكون كالتالي:
ألم أو حرقة في أعلى البطن
غثيان أو شعور بالامتلاء بعد الأكل
فقدان شهية أو وزن
تجشؤ مستمر أو رائحة فم كريهة
في الحالات المتقدمة: قيء دموي أو براز أسود (علامة على نزيف داخلي)
كيف يتم تشخيص جرثومة المعدة؟
يعتمد الطبيب على واحد أو أكثر من الفحوصات التالية
تحليل البراز للكشف عن البكتيريا
تحليل الدم للأجسام المضادة
اختبار التنفس (Urea Breath Test): الأكثر دقة
منظار المعدة: يُستخدم في الحالات المتقدمة أو غير المستجيبة للعلاج

ما هو علاج جرثومة المعدة؟
العلاج التقليدي يسمى "العلاج الثلاثي"، ويستمر لمدة 10 – 14 يومًا، ويتضمن:
مضاد حيوي 1: كلاريثرومايسين أو ميترونيدازول
مضاد حيوي 2: أموكسيسيلين أو تينيدازول
مثبط مضخة البروتون (PPI): مثل أوميبرازول أو إيزوميبرازول
أحيانًا يُضاف علاج رابع (بيزموث) في الحالات المقاومة
من الضروري إكمال الكورس بالكامل
لا توقف العلاج عند تحسن الأعراض فقط
نصائح أثناء فترة العلاج
تجنب القهوة والمشروبات الغازية
قلل من الأطعمة الحارة والمقلية
أكثر من شرب الماء
لا تتناول مضادات حيوية بدون وصف طبي
تابع مع الطبيب بعد العلاج لإعادة الفحص والتأكد من الشفاء
ماذا لو لم تُعالج الجرثومة؟
الإهمال في علاج جرثومة المعدة قد يؤدي إلى:
قرحة في المعدة أو الاثني عشر
نزيف هضمي داخلي
التهابات مزمنة في المعدة
زيادة خطر الإصابة بسرطان المعدة في حالات نادرة
هل هناك علاج طبيعي أو أعشاب فعالة؟
بعض الأعشاب مثل: العرقسوس، البروبوليس، الزنجبيل، والشاي الأخضر أظهرت نشاطًا مضادًا لجرثومة المعدة، لكنها ليست بديلة عن العلاج الطبي.
يمكن استخدامها كمساعد بعد استشارة الطبيب، خصوصًا بعد الانتهاء من الكورس العلاجي.
الأسئلة الشائعة حول جرثومة المعدة
1. ما هي أعراض جرثومة المعدة؟
أشهر الأعراض: ألم أو حرقان بالمعدة، انتفاخ، غثيان، فقدان شهية، أحيانًا قيء أو نقص وزن. وفي بعض الحالات لا تظهر أي أعراض.
2. هل جرثومة المعدة معدية؟
نعم، تنتقل غالبًا عن طريق الطعام أو الماء الملوث أو عن طريق اللعاب، لذلك الاهتمام بالنظافة الشخصية مهم جدًا للوقاية.
3. هل جرثومة المعدة تسبب سرطان المعدة؟
وجودها لفترة طويلة بدون علاج قد يسبب قرحة المعدة ويزيد خطر الإصابة بسرطان المعدة بنسبة معينة، لكن ليس كل من لديه جرثومة سيصاب.
4. ما هو أفضل علاج لجرثومة المعدة؟
العلاج الموصى به غالبًا هو العلاج الثلاثي أو الرباعي: يشمل مضادين حيويين مع دواء يقلل حموضة المعدة، ويؤخذ لفترة 10–14 يومًا.
5. هل يمكن أن تعود جرثومة المعدة بعد العلاج؟
نعم، قد تعود إذا لم يتم القضاء عليها بالكامل أو إذا حدثت عدوى جديدة. لذلك من المهم عمل اختبار بعد العلاج للتأكد من الشفاء.
6. هل الأدوية وحدها تكفي لعلاج جرثومة المعدة؟
الأدوية هي الأساس، لكن يُنصح أيضًا بتغيير نمط الحياة: تجنب التدخين، تقليل الكافيين، وتجنب الأطعمة الحارة والدسمة.
7. كيف يتم تشخيص جرثومة المعدة؟
عن طريق اختبار التنفس باليوريا، أو تحليل البراز، أو منظار المعدة مع أخذ عينة.
خلاصة المقال
جرثومة المعدة عدوى منتشرة، لكنها قابلة للعلاج الكامل إذا تم تشخيصها مبكرًا.
لا تهمل الأعراض، ولا تستهين بها حتى لو كانت بسيطة، خاصة إن كنت تعاني من مشاكل مزمنة في المعدة.
المفتاح هو: التشخيص الدقيق + التزام بخطة العلاج + المتابعة بعد الشفاء.
المصادر
Mayo Clinic
American Gastroenterological Association
WHO – Helicobacter pylori fact sheet
روابط ذات صلة